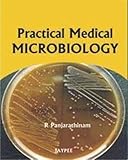
Amazon cover image

Practical medical micro biology
Material type: TextLanguage: English Publication details: Usa Jaypee brothers medical publishers p ltd 2009Edition: 1stDescription: 162ISBN:
TextLanguage: English Publication details: Usa Jaypee brothers medical publishers p ltd 2009Edition: 1stDescription: 162ISBN: - 9788184486988
- 616.07 PAN/PR
| Item type | Current library | Collection | Call number | Status | Date due | Barcode | |
|---|---|---|---|---|---|---|---|
 Books
Books
|
VPSVAC Central Library | MODERN MEDICAL | 616.07 PAN/PR (Browse shelf(Opens below)) | Available | 15660 |
There are no comments on this title.
Log in to your account to post a comment.